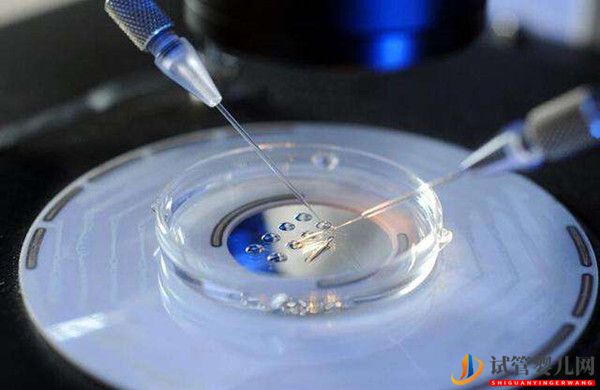
俄羅斯試管嬰兒養(yǎng)囊胚是怎樣的？(圖1)

俄羅斯試管嬰兒養(yǎng)囊胚是怎樣的?

(三代試管)試管嬰兒是需要將培育好的胚胎移植到子宮內(nèi)讓其著床,所以胚胎在這個(gè)生殖技術(shù)流程中是很重要的,試管嬰兒的胚胎能夠衍生出很多相關(guān)問題,例如養(yǎng)囊胚,這是試管嬰兒胚胎的一種情況,那試管嬰兒養(yǎng)囊胚究竟是什么呢?
一、胚胎過程
試管嬰兒治療的步驟包括:進(jìn)入促排---B超監(jiān)測---決定打破卵針時(shí)間---取卵--取精---體外受精---胚胎培養(yǎng)---胚胎移植---黃體藥物補(bǔ)充---驗(yàn)孕。
通常情況下正常受精是一個(gè)卵子和一個(gè)精子結(jié)合形成受精卵(2PN;two pronuclear),第一天早上看到2PN,表示正常受精成功,這些受精卵才可發(fā)育成有用的胚胎。
(三代試管)受精卵的發(fā)育,通常情況前三天個(gè)分裂一次,到第三天會到八個(gè)細(xì)胞的胚胎。第四天,繼續(xù)分裂成很多細(xì)胞,已不好數(shù)細(xì)胞數(shù),而形狀像是桑葚(桑葚期胚胎);第五天則有更多細(xì)胞,并在細(xì)胞中形成囊腔(囊胚期胚胎)。
所以說,囊胚是胚胎的一個(gè)時(shí)期,一般要在培養(yǎng)箱內(nèi)培養(yǎng)到第五天,甚至有些胚胎長的慢一點(diǎn),會到第六天才長到囊胚期胚胎。
新胚與冷胚,就是胚胎經(jīng)過冷凍保存起來,都叫凍胚;而沒有經(jīng)過冷凍的胚胎,都叫鮮胚。
適不適合養(yǎng)囊胚?
到底患者的胚胎要不要養(yǎng)到囊胚?這是一個(gè)(三代試管)存在很多不孕患者心中都會有的疑問。要回答要不要養(yǎng)到囊胚?先看看患者適不適合養(yǎng)囊胚咯。
養(yǎng)囊胚的過程中逐漸淘汰掉一些胚胎,可能導(dǎo)致最后沒有可用胚胎。如果還有可用的胚胎那就是相對較優(yōu)質(zhì)的胚胎。
通常情況下,試管嬰兒中心會制訂他們是否養(yǎng)囊胚的標(biāo)準(zhǔn),大部分中心會根據(jù)第三天胚胎的數(shù)量和質(zhì)量來決定,當(dāng)有足夠多且優(yōu)質(zhì)的第三天胚胎,會建議繼續(xù)養(yǎng)囊胚,從中再精挑出更優(yōu)質(zhì)的胚胎,當(dāng)然最終的胚胎數(shù)也會因此減少。
三、要不要養(yǎng)囊胚
囊胚培養(yǎng)最大的優(yōu)點(diǎn)就是胚胎選擇,(三代試管)也就是通過更長時(shí)間的體外培養(yǎng),一些潛力較不優(yōu)良的胚胎,會停止生長,留到最后都是較優(yōu)良的胚胎,但這也是他的缺點(diǎn),可用胚胎數(shù)會減少。
目前實(shí)驗(yàn)培養(yǎng)環(huán)境是已非常進(jìn)步,但并不是完美,有些有可能正常懷孕生產(chǎn)的胚胎,因多培養(yǎng)幾天而淘汰掉,因此可用胚胎會減少。
囊胚是更挑選過的胚胎,所以囊胚移植后成功著床懷孕活產(chǎn)的機(jī)率會較第三天的胚胎還高,但因可用胚胎較少,一次促排下來的移植次數(shù)較少,所以一次促排的累積懷孕活產(chǎn)率會較低。
囊胚可挑出更好的胚胎,單一囊胚的著床率更高,所以可以減少移植的胚胎數(shù),有些中心甚至只移植一個(gè)優(yōu)質(zhì)囊胚,就可達(dá)到不錯(cuò)的成功率,從而避免多胞胎妊娠的產(chǎn)生。





